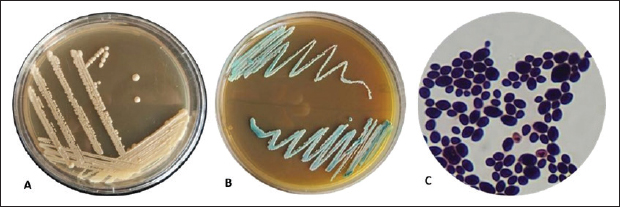
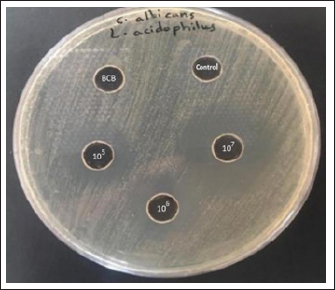

| Research Article | ||
Open Vet. J.. 2026; 16(3): 1678-1686 Open Veterinary Journal, (2026), Vol. 16(3): 1678-1686 Research Article Lactobacillus acidophilus as an antifungal against Candida albicans isolated from Pycnonotus goiavier (Yellow-Vented Bulbul) thrushHuda A. H. Qader1, Nabaa Ali Abd Alradha Al_Saeedi1, Salam Mohammed Khlaif Al-Tamimi1, Hawraa F. H. Al-Abedi2* and Israa Ibrahim Khalil31Department of Biology, College of Science, University of Wasit, Wasit, Iraq 2Department of Biology, College of Education for Pure Sciences, University of Al-Hamdaniya, Nineveh, Iraq 3Department of Microbiology, College of Veterinary Medicine, University of Mosul, Mosul, Iraq *Corresponding Author: Hawraa F. H. Al-Abedi. Department of Biology, College of Education for Pure Sciences, University of Al-Hamdaniya, Nineveh, Iraq. Email: hawraafaisal [at] uohamdaniya.edu.iq Submitted: 12/10/2025 Revised: 10/01/2026 Accepted: 18/01/2026 Published: 31/03/2026 © 2026 Open Veterinary Journal
AbstractBackground: Candida albicans is an opportunistic yeast located in the avian digestive system. It is the causal agent of candidiasis, an important yeast infection. Aim: This study aims to identify C. albicans from mouth sores in yellow-vented Bulbuls using standard and advanced techniques. Methods: This study included 50 oral swabs from white lesions in yellow-vented Bulbul birds, which were analyzed analysed using standard methods. Results: Candida albicans was found in 15 out of 50 samples (30%). Candida albicans identification was confirmed using polymerase chain reaction (PCR), and the 18S rRNA gene was found in 15 isolates (100%). The antifungal profile of C. albicans was evaluated according to the antifungal disc diffusion method against clotrimazole, ketoconazole, amphotericin B, itraconazole, and fluorcytosine. Fourteen C. albicans isolates were sensitive to clotrimazole (93.3%), ketoconazole, and fluorcytosine 10 (66.6%), while they were resistant to amphotersin B (15/100%). The commercially important probiotic, Lactobacillus acidophilus, was identified phenotypically and molecularly by PCR (16SLAuni) in 5 of 50 sheep milk samples (10%). The antifungal activity of the L. acidophilus against isolated C. albicans was evaluated using the agar well diffusion method. Lactobacillus acidophilus cell-free neutralized supernatant was used at concentrations (105, 106, 107). The most effective inhibition zone was at (107), and it was suppressed to 12 C. albicans isolates. Conclusion: It is also concluded that the antifungal activity of both clotrimazole and L. acidophilus is not significantly different, the significance rate for all experiments was considered as p values under 0.05, which presented as average ± SEM. Regarding the uniqueness of our research in terms of the host from which the pathogenic fungi were isolated, further studies are recommended. Keywords: Candia albicans, Lactobacillus acidophilus, Antifungal, Pycnonotus goiavier, Thrush. IntroductionCandidosis (candidiasis, thrush) is a global fungal illness that affects humans and animals, particularly birds. It is mostly caused by Candida albicans, which exists as a microbiota in both hosts. Most candidal infections are endogenous (Acurcio et al., 2014; Al-Abedi et al., 2023). Candida spp. may proliferate in cases of immunosuppression or extended broad-spectrum antibiotics (Al-Abedi et al., 2023; Al-Abedi et al., 2024). Thrush typically presents as a nonhealing ulcer, characterized by a white-gray plaque in the oral cavity and alimentary tract (Allonsius et al., 2019; Alhasan et al., 2022). In birds, Candida may infect the respiratory tract, central nervous system, digestive tract, skin, and other organs. Invasive infections are more likely to occur in people with weakened immune systems due to viral infections, corticosteroid treatment, long-term use of antibiotics, and hidden malnutrition (Anas et al., 2008). The swift and precise identification of the pathogenic fungi is crucial. Conventional identification of pathogenic fungi relies on morphological and physiological assessments that frequently require 3 days or longer and may yield erroneous results. A traditional polymerase chain reaction (PCR) technology was recently developed to simultaneously classify many fungal infections within a single mycological result (Balouiri et al., 2016). Ribosomal DNA sequence analysis is a widely utilised molecular method for swiftly identifying fungi (Cejudo et al., 2010; CLSI, 2017). LAB constitute a significant industrial category used as starting cultures in the production of fermented dairy products, including yogurt and cheeses (CLSI, 2017). Lactic acid bacteria (Lactobacillus) are effective prokaryotes that demonstrate antibacterial and antifungal characteristics (FAO/WHO, 2002). They produce endogenous microbiocidal chemicals, including lactic acid, bacitracin, and hydrogen peroxide, which exhibit microbiocidal effects, as well as bacteriocins such as small heat-stable antibiotics, larger heat-labile proteins, and complex bacteriocins containing one or several chemical components. Thus, it can be useful for controlling and treating of different Candida infections (Gil et al., 2010). Different types of bacteria, like Bifidobacterium, Streptococcus, and Lactobacillus, are known as probiotics and are considered safe and non- harmful, with Lactobacillus spp. being the main probiotic used in medicine and industry. Lactobacillus spp. is a diverse group of about 145 types of bacteria that are rod-shaped, do not form spores and can live in low-oxygen or very low-oxygen conditions. Dairy and fermented foods use Lactobacillus to improve health. Diverse locations, including the environment and the human body (oral cavity, gastrointestinal tract, and vaginal tract), harbor Lactobacillus spp (Al-abedi et al., 2020). The inhibitory activity of probiotic microorganisms against pathogens is a defining property against pathogens is a defining property of probiotic microorganisms (Al-abedi et al., 2020). Probiotics help fight harmful germs by making it harder for them to grow and by producing substances that are not good for these germs, such as hydrogen peroxide and bacteriocins (Al-abedi et al., 2020). Resistance identification, epidemiological research, and in vitro effectiveness assessment of both new and well-established antifungal medications all depend on antifungal susceptibility testing (Al-abedi et al., 2020). This study aims to identify Candida albicans from mouth sores in Yellow-Vented Bulbuls using standard and advanced techniques and find and identify C. albicans from mouth sores in Yellow-Vented Bulbuls using standard and advanced techniques, and identify Lactobacillus spp. from healthy sheep’s milk using advanced methods. Furthermore, insights gained from the efficacy of Lactobacillus acidophilus in combating C. albicans may lead to novel probiotic applications in veterinary and human health. Materials and MethodsEthical approvalThe Animal Welfare Committee of Mosul University—College of Veterinary Medicine, reference number UM.VET.2025.010, directed the ethical euthanasia of the samples after owner agreement. Sample collectionFrom numerous bird shops in Bartella, Mosul Governorate, 50 swab samples were taken from the oral cavities of yellow-vented bulbuls, which have a cheesy crop. Materials were maintained in sterile polyethylene tubes in an icebox and transported to the laboratory for mycological evaluation under strict aseptic conditions. Isolation of Candida albicansThe yellow-vented Bulbul oral cavity swabs were inoculated into Sabouraud dextrose agar with chloramphenicol and cultivated at 37°C for 24–48 hours before being transferred to Candida chromogenic agar plates and incubated at 37°C for 48 hours (Al-abedi et al., 2019). Macroscopic and microscopicallyThe rapid growth, morphology, texture, and pigmentation of colonies on specialized culture plates (Candida chromogenic agar) are intended to facilitate the isolation and identification of C albicans (Jørgensen et al., 2017; Ji-Hee et al., 2022). Looking at the colonies under a microscope with lactophenol cotton blue shows that they are round to oval and have budding cells, which is typical for budding-producing yeast (Al-abedi et al., 2019). Molecular identification of C. albicansThe conventional PCR method was used to amplify 18S rRNAgene using specified primer sequences. DNA extraction was conducted as per reference (Jørgensen et al., 2017). We then performed PCR using oligonucleotide primers equivalent to a base pair fragment. The primers used in PCR were supplied by South Korea Company, Table 1. Table 1. PCR identification of gene primers, with nucleotide sequences and product sizes.
The master mix was prepared by mixing 3 μl of template DNA, 1 μl of forward primer, 1 μl of reverse primer (both at 10 pmol), and 20 μl of nuclease-free water according to the manufacturer instructions. The PCR equipment was set up for 30 cycles (Table 2). The PCR results were electrophoresed on an agarose gel for 1 hours at 100 V and visualized using a gel documentation system. Table 2. PCR program setting for Candida albicans.
Isolation of Lactobacillus acidophilusFifty sheep milk samples were collected from ovine agricultural areas in Bartella, Mosul Governorate. To isolate L. acidophilus, 1 ml of the sample was aseptically combined with 9 ml of sterile distilled water for 1–3 minutes. Serial dilutions (10-¹ to 10-6) were prepared for each specimen. 1 ml from the right dilution was placed on DeMan Rogosa and Sharpe (MRS) agar De and kept at 37°C in an anaerobic culture jar for 48 hours. Small and pure white colonies (2–3 mm wide) with smooth edges were selected and sub cultured on to a new MRS agar plate (Jørgensen et al., 2017). Identification of L. acidophilusLactobacillus acidophilus was identified based on its morphological, cultural, and biochemical properties (Jørgensen et al., 2017). Lactobacillus acidophilus confirmation by PCR assayWe used standard PCR to amplify the 16S universal primer (16S_uni) targeting a 277 bp area with five spacers (1–5). The amplification conditions are listed in Tables 3 and 4, respectively, according to (Khalil et al., 2019; Khalil, 2021). Table 3. Primer sets for Lactobacillus acidophilus species.
Table 4. Amplification conditions for Lactobacillus acidophilus species.
Evaluation of the antifungal efficacy of probiotic bacteria (Lactobacillus acidophilus) against C. albicans via agar well diffusionThe 50 isolated C. albicans isolates were tested for L. acidophilus susceptibility as an antifungal agent (Ji-Hee et al., 2022). Tubes containing 9 ml of brain heart infusion broth were prepared for the culturing of Lactobacillus bacteria. A tenfold serial dilution series (10-¹ to 10-7) was equipped, 1 μl of each dilution was injected into DeMan Rogosa and Sharpe agar and incubated on triplicate plates at 37ºC for 24 hours. The mean CFU count was calculated for suspensions with concentrations of 105, 106, and 107 cells per milliliter (CFU ml-¹). Lactobacillus was cultivated on MRS agar at 105, 106, and 107 CFU ml1 for 18–24 hours at 37°C with 5% CO`7, then transferred to MRS broth for BCB. After 24 hours, we centrifuged the culture for 10 minutes at 10,000 rpm to obtain the cell-free supernatant (CFS). After passing through a millipore filter (0.22 μm), Lactobacillus acidophilus CFS was adjusted to pH 7.0 ± 0.2 using 1M NaOH. Candida albicans were cultured in nutrient broth at 37°C for 18–24 hours. Petri dishes containing 20 ml of nutrient agar were filled with 100 μl of C. albicans broth culture using a spreading method. The plates were then left at room temperature for 1 hour, and holes were made in the agar using a cork borer. Fifty μl of Fresh MRSB aliquots used as control were added to one well, and the others were filled with neutralized CFS of Lactobacillus culture broth (105, 106, 107) . Agar plates were incubated at 37°C for 24 hours. Vernier callipers measured inhibitory zone diameters (mm) after incubation. The isolates were negative (-), positive (+), moderate (++), and strong (+++) (Ji-Hee et al., 2022). Susceptibility to some antifungal drugsCandida albicans isolates were subjected to the following antifungals: clotrimazole, ketoconazole, amphotericin B, itraconazole, and fluorocytosine using the standard disc diffusion method. This was done using the standard reference technique of the National Committee for Clinical Laboratory Standards (Mugale et al., 2015). The inhibition zone was measured, and the results were stabilized (Oliveira et al., 2016). ResultsMacroscopic and microscopical examinationThe samples collected from the oral cavity of yellow-vented bulbul, (50) swabs were investigated for C. albicans species. Of the 50 samples, 15(15/50) were positive for Candida albicans (30%). Based on the colony morphology on Sabouraud′s Dextrose Agar and Candida Chromogenic Agar (CCA), microscopically examined as shown in Figure 1.
Fig. 1. A. white, smooth, creamy colonies, circular and concave on Sabouraud Dextrose agar, B. Green colonies were identified as C. albicans on Candida Chromogenic Agar, C. Lactophenol cotton blue stained Candidal cells examined by 100 X (oil immersion), buddy yeast cells oval to spherical. Polymerase chain reactionA section of the mitochondrial gene that encodes the major subunit of the 18S rRNA gene was amplified for C. albicans using specific primer sequences. The molecular identification of isolated C. albicans was 15 out of 15 (100%), and 415 bp amplicons were visualized on a 1.5% agarose gel (Fig. 2).
Fig. 2. PCR product analysis of pathogenic C. albicans by agarose gel electrophoresis. Lane M Marker ladder (800 bp), lane (1–9): 18SrRNA gene at 415 bp. Isolation and identification of L. acidophilusFive L. acidophilus out of 50 (10%) were isolated from apparently healthy sheep milk samples based on depending upon morphological characteristics as gram positive, catalase negative, and microscopic examination, as shown in (Fig. 3). As the 5 isolated were tested also tested by molecular technique PCR using 16S_LAuni showing (100%) giving positive results (Fig. 4).
Fig. 3. Gram stain Lactobacillus spp., long rods shaped bacilli under 100X (Oil immersion). Antifungal profile for C. albicans
Fig. 4. The PCR product of the 16S_LAuni gene from Lactobacillus acidophilus is analysed using agarose electrophoresis. Lane 1: Molecular size marker (1,000 bp); Lanes 1–5: 16S _LAuni gene amplicons 277 bp. The antibiotic disc diffusion method was used to determine the antifungal profile of all (15) isolated C. albicans. The response of the isolates to clotrimazole isolates (10 µg), ketoconazole (10 µg), amphotericin B (10 µg), itraconazole (10 µg), and flucytosine (0.5 µg). was evaluated. The inhibition zones surrounding the disc were quantified and contrasted with breakpoints, following the manufacturers guidelines (DHN PAN Krakow, Poland). of the samples tested, 93.3% were sensitive to clotrimazole, 66.6% to ketoconazole, and 33.3% to itraconazole, but all were resistant to amphotericin B (100%), as detailed antifungal profile of C. albicans in Table 5 and illustrated in (Fig. 5).
Fig. 5. Antifungal sensitivity pattern for C. albicans. Table 5. Antifungal profile of Candida albicans.
The inhibition results were also compared between Clotrimazole and the inhibitory effect of L. acidophilus bacteria against the isolated C. albicans visually and statistically explained in the Table 6. Table 6. Number of inhibited Candida albicans isolates with Clotrimazole and (CFS) of probiotic Lactobacillus acidophilus at concentration 107.
Antifungal activity evaluation probiotic (Lactobacillus acidophilus)The agar well diffusion methods demonstrated that L. acidophilus cell-free liquid at three concentrations (105, 106, 107) inhibited the growth of C. albicans. Three levels of Lactobacillus acidophilus were tested: C albicans was inhibited best at the CSF concentration (107), as it shown in (Fig. 6). The inhibition results were compared specifically with clotrimazole, as the isolates showed clear sensitivity to this antifungal agent. These results were documented by stabilizing the diameters of the inhibition for both L. acidophilus and clortimazole with similar values as 9 mm for L acidophilus at the CSF concentration (107) and 10 mm for clotrimazole.
Fig. 6. BCB: Broth culture bacteria (Lactobacillus acidophilus), Control: (MRS broth), The cell free supernatant (CSF) of Lactobacillus acidophilus (105,106,107), obvious zone of C. albicans growth inhibition at (107). Statistical analysisResults were analyzed using analysis of variance and least significant difference, with p values under 0.05 considered significant [30]. The results are presented as average ± SEM DiscussionEnteric infection is the predominant type of candidiasis, primarily affecting the crop, although the oral cavity, proventriculus, and ventriculus are affected. This study employed a thorough methodology to identify C. albicans isolates from the oral cavities of yellow-vented bulbuls, as research on this bird species remains limited concerning the isolation of Candida fungus (FAO/WHO, 2002). Of the 50 (30%) oral cavity swab samples was the most prevalent isolated species that caused Candidiasis (Thrush) in yellow-vented bulbul. The presence of C. albicans was higher compared with the published work in Diyala Governorate, which includes isolation of C. albicans yeasts from domestic chickens (Petricevic et al., 2021). Recent studies have shown that C. albicans, can settle in specific areas and spread to other areas when conditions are suitable and infecting different bird species (Razmyar et al., 2014). Five L. acidophilus isolates from 50 (10%) milk samples from apparently healthy sheep matched those from Mosul, Iraq, and Delhi, India, using the 16S_uni detection technique (Samour. and Naldo 2002; Salari et al., 2020). Lactobacillus alters the microbiota makeup and quality of raw milk. Lactic acid bacteria such as Lactobacillus casei, Lactobacillus plantarum, Lactobacillus rhamnosus, Lactobacillus curvatus, Lactobacillus brevis, Lactobacillus fermentum, Leuconostoc lactis, L. acidophilus, Lactobacillus cremoris, Enterococcus faecium, Enterococcus faecalis, and Enterococcus durans are the microflora of raw milk (Samour and Naldo, 2002). As per the FAO WHO (2002), the optimal attributes of a Lactobacillus probiotic strain are as follows: The strain should be nonpathogenic, stable in acidic conditions and in the presence of bile, capable of adhering to human mucosa, able to colonize the intestine, maintain viability throughout storage and usage, exhibit favorable physiological effects, and be deemed safe for use. A documented rise in antifungal medication resistance has accompanied the increasing prevalence of fungal infections (Ji-Hee et al., 2022). The increasing resistance of candida species to standard antifungal drugs makes it more important to research new treatments for Candida-related diseases, like probiotics. Probiotic therapy helps restore the natural balance of the microbiota, offering benefits over traditional antifungals because they do not develop any resistance, are safe at the right doses, and do not have any side effects (Al-abedi et al., 2023; Silva et al., 2016). The present investigation demonstrated that the CFS obtained from Lactobacillus acidophilus (at doses of 105, 106, and 107) inhibited the development of C. albicans using the agar diffusion method. Numerous investigations have shown that lactobacilli exhibit antifungal properties against various Candida species, and the results were similar to those of some researchers relating the diameter of inhibition zones made around the isolated C albicans by L. acidophilus with the same value of approximately 9 mm (Steve, 2016). Agar well diffusion is a simple and dependable way to test how well different probiotics can fight against Candida species (Tabasco et al., 2007). The benefit of this approach is its applicability to various probiotic concentrations of probiotics within a plate. The most effective concentration for L. acidophilus was 107, which also exhibited the optimal inhibition of zone at this dosage. Probiotics reduce Candida colonization and infection. The anticandidal effect of such microorganisms is primarily due to the production of lactic acid, hydrogen peroxide, and acetic acid, which can inhibit the growth of Candida species. Conversely, L. crispatus had the highest co-aggregation levels with C. albicans (Vieira and Coutinho, 2009). Salari et al., (2020) found that L. acidophilus and L. plantarum, when present in large numbers (between 1010 and 102 CFU/ml), reduced the growth of most oral Candida species, except for C. albicans and some types of C. krusei (Vijay and Mahendra, 2006). The difference in results may be affected by many factors, such as differences in host physiology, study conditions, and the chosen probiotic dose. Our results indicate that lactobacilli inhibit Candida proliferation and biofilm formation while also alleviating the symptoms of invasive fungal infections (Vieira and Coutinho, 2009). Probiotics, including Lactobacillus, Bifidobacterium, and Streptococcus spp., are acknowledged for their ability to prevent the growth of many intestinal infections in humans. Furthermore, it exerts beneficial effects against conditions arising from gut microbiota dysbiosis (this makes it competitive in terms of its pharmacological effectiveness with other traditional antifungal drugs. Antifungal profile of Candida isolates in the current study and according to the antibiotic disc diffusion method applied for each of clotrimazole, ketoconazole, amphotericin B, itraconazole, and flucytosine on all isolated C. albicans (Tabasco et al., 2007). All isolates were resistant to amphotericin B 15 (100%), whereas about 14 (93.3%) isolates were sensitive to clotrimazole, but a small proportion of isolated C. albicans were sensitive to ketoconazole and Fluorcytosine 10 (66.6%). In this study, we evaluated the antifungal activity of L. acidophilus as a probiotic against isolated pathogenic C. albicans and compared the inhibition results with the effect of the chosen antifungals in discs. The results were very close to clotrimazole. This indicates the effectiveness of probiotic bacteria and the possibility of replacing traditional drugs, which have side effects, if modern studies take this approach. ConclusionThe evaluation of the antifungal properties of probiotic bacteria, particularly L. acidophilus, has yielded promising results against C. albicans as a natural antifungal agent. The application of the agar well diffusion method provided clear evidence of this efficacy. Notably, the most inhibited effect was recorded at a concentration of 107 L. acidophilus, highlighting an optimal threshold for its antifungal activity. It was also found to be equally effective as clotrimazole, and preferable of L. acidophilus, which maintains a balanced microbiome and inhibits pathogenic growth, recording the possibility for merging conventional and alternative medicines and the need for more research to understand and enhance treatment regimens. These findings allow for more comprehensive fungal infection management. Further research is needed to determine the mechanisms of L. acidophilus and other lactobacillus bacteria as antifungal and test them against various fungal species in infected experimental animals (in vivo studies). AcknowledgmentsIraq helped us do this study, which we appreciate. Also, we applaud all scientists and researchers for helping humanity. Conflict of interest The authors declare no conflict of interest. Authors’ contributions Hawraa Faisal: Conceived and designed the study, wrote the first draft of the manuscript, and created the illustrations. Israa Ibrahim Khalil: Critically reviewed the manuscript and secured funding. Huda Abdulhadi Qader: was responsible for performing and documenting the molecular techniques applied in this research. Nabaa Ali Abdulredha Al-Saeedi: Wrote one of the topics and secured funding. Salam Mohammed Khalif: Wrote one of the topics and critically reviewed the manuscript. Data availability
ReferencesA.S., C.A.T.O., ., I.H.N.B. and ., A.S.T. 2004. Antimicrobial activities of lactic acid bacteria strains isolated from Burkina Faso Fermented milk. Pak. J. Nutr. 3, 174–179; doi: 10.3923/pjn.2004.174.179 Acurcio, L.B., Souza, M.R., Nunes, A.C., Oliveira, D.L.S., Sandes, S.H.C. and Alvim, L.B. 2014. Isolation, enumeration, molecular identification and probiotic potential evaluation of lactic acid bacteria isolated from sheep milk. Arq. Bras. Med. Vet. Zootec. 66(3), 940–948; doi:10.1590/1678-41625796 Al-Aalim, A.M., Al-Chalaby, A.Y. and Al-Abedi, S.F. 2024. Isolation and identification of Klebsiella pneumoniae from respiratory disease in chicken. Iraqi. J. Vet. Sci. 38(3), 583–588; doi:10.33899/ijvs.2024.144877.3335 AL-abedi, F.H, Bassam, Y.K., Azhar, A.F.A.L 2020. Evalution The Antifungal Activity of Lactobacillus Against Some isolates of Candida spp Isolated from Bovine Mycotic Mastitis. A Thesis Submitted to the Council of College of Veterinary Medicine University of Basrah In Partial Fulfillment of the Requirements for the Degree of Doctorate of Philosophy in Veterinary Microbiology. 38. https://www.researchgate.net/publication/347437990. Al-abedi, F.H., Azhar, A.F., Al-Attraqch.. and Bassam Y Khudaier. 2020a. Anti-pathogenic candida spp. activity determination via lactobacillus spp. isolation and identifications using conventional and molecular methods. Basrah. J. Vet. Res. 19(3), doi: 10.23975/bjvetr.2020.174103 Al-abedi, F.H., Azhar, A.F.A.L. and Bassam, Y.K.H. 2020b. Investigation of the hydrolytic enzyme activities of Candida Parapsilosis isolated from milk samples of bovine mastitis by API ZYM and molecular method. Indian. J. Forensic. Med. Toxicol. 14(3), 515–520; doi:10.37506/ijfmt.v14i3.10803 AL-abedi, F.H., Bassam, Y.K. and Azhar, A.F. 2020b. Phenotypic and genotypic characterization of lactobacillus species isolated from apparently healthy cow milk, Basrah/ Iraq. Bas. J. Vet. Res. 19(1), 10–20. Available via: https://www.researchgate.net/profile/ Bassam-Khudaier/publication/338545128 AL-Abedi, F.H., Bassam, Y.K.H. and Azhar, A.F.A.L. 2019. Conventional and molecular detection of Candida albicans and Candida parapasilosis isolated from bovine mastitis in Basrah-Iraq. Biochem. Cell. Arch. 19(2), 3285–3289; doi:10.35124/bca.2019.19.2.3285 Al-Abedi, H.F., Khalil, I.I., Atheer, Q.M.A. and ThAl, W. 2023. Morphological, molecular investigation of fungi isolated from layers poultry and their environment with their mycotoxins profile in Waist province. J. Glob. Innov. Agric. Sci. 11(2), 141–146; doi:10.22194/JGIAS/23.1077. Al-Abedi, H.F.H., Khalil, I.I. and Al-Abedi, S.F.H. 2024. Molecular detection of Virulence Factor Genes in Candida albicans Isolated from the Oral Cavity of Local Chicken and Antifungal Susceptibility in Mosul Province. Al-Kitab J. For Pure Sci. 8(2). Al-Abedi, S., Hussien, T. and Ali, A. 2023. Molecular Detection of Candida tropicalis Isolated from Buffalo’s Genitalia in Wasit Province. Egypt. J. Vet. Sci. 54(4), 715–721; doi:10.21608/EJVS.2023.202071.1470 Alhasan, D.A. Al-Abedi, H.F., Hussein. and Mohammad, Ali. A.Q. 2022. Morphological detection of dermatophytes isolated from cattle in Waist province. Iraqi J. Vet. Sci. Vol. 36(I).167–172; doi: 10.33899/ijvs.2022.135833.2530. Allonsius, C.N., Vandenheluvel, D., Oerlemans, E.F.M., Petrova, M.I., Donders, G.G.G., Cos, P., Delputte, P. and Lebeer, S. 2019. Inhibition of Candida albicans morphogenesis by chitinase Lactobacillus rhamnosus GG. Sci. Rep. 9(9), 2900; doi:10.1038/s41598-019-39625-0 Anas, M., Eddine, H.J. and Mebrouk, K. 2008. Antimicrobial Activity of Lactobacillus Species Isolated from Algerian Raw Goat’s Milk Against Staphylococcus aureus. World. J. Dairy. Food. Sci. 3(2), 39–49; https://www.doi.org/wjdfs/wjdfs3(2)/3.pdf Balouiri, M., Sadiki, M. and Ibnsouda, S.K. 2016. Methods for In Vitro Evaluation Antimicrobial Activity: a Review. J. Pharm. Anal. 6, 71–79; doi:10.1016/j.jpha.2015.11.005 Bluma., A. and Ciprovica, I. 2015. Diversity of lactic acid bacteria in raw milk. Res. For. Rural. Develop. 1, 1691–4031; doi:10.13140/RG.2.2.32862.72006 Cejudo, T.G., Gallego, A.G., Lacasa, E.C., Aller, A.I., Romero, A., García, J.P., Andrés, G.Q. and Martín-mazuelos, E. 2010. Evaluation of the VITEK 2 system to test the susceptibility of Candida spp. Trichosporon asahii and Cryptococcus neoformans to amphotericin B, fluconazole and voriconazole: a comparison with the M27-A3 reference method. Med. Mycology. 48(5), 710–719; doi:10.3109/13693780903473343 Clsi. 2017. Performance standards for antifungal susceptibility testing of yeasts. 1st ed. CLSI supplement M60. Wayne, PA: Clinical and Laboratory Standards Institute, ; doi:10.1128/CMR.00069-19 FAO/WHO (2002). Guidelines for the Evaluation of Probiotics in Food. London, Ontario: Food and Agriculture Organization of the United Nations and World Health Organization Working Group Report: 1–11. Available via https://isappscience.org/wp-content/uploads/2019/04/probiotic_guidelines.pdf. Garces, A. 2023. Candidiasis in Birds: an Update. J. Vet. Physiol. Pathol. 2(3), 42–46. Gil, N.F., Martinez, R.C.R., Gomes, B.C., Nomizo, A. and Martinis, E.C.P.D. 2010. Vaginal lactobacilli as potential probiotics against Candida spp. Braz. J. Microbiol. 41, 6–14; doi:10.1590/S1517-83822010000100002 Hasab Allh, H.F. and Alhasan, D.A. 2023. Detection of the compounds produced from Rhizopus oryzae. Iraqi J. Vet. Sci. 37(3), 611–617; doi:10.33899/ijvs.2023.135462.2484 Ji-Hee, S., HCh, W., Yong, S.P. and Young, D.N. 2022. Detection and identification of Lactobacillus acidophilus species and its commercial probiotic strains using CRISPR loci-based amplicon analysis. LWT. Food. Sci. Technol. 171, 114166; doi:10.1016/j.lwt.2022.114166 Jørgensen, M.R., Kragelund, C., Jensen, P.Ø., Keller, M.K. and Twetman, S. 2017. Probiotic Lactobacillus reuteri has antifungal effects on oral Candida species in vitro. J. Oral Microbiol. 9, 1–8; doi:10.1080/20002297.2016.1274582 Kadhim, M.A., Abdulameer, S.J., Al-Dulaimi, O.G.J. and Al-Azzawi, A.K. 2024. Isolation and Molecular Identification of Candida albicans from the Oral cavity of Domestic Chickens using 28S rDNA in Diyala Governorate, Iraq. J. World Poult. Res. 14(2), 131; doi:10.36380/jwpr.2024.12.PII:S2322455X2400012-14 Khalil, A., Sepehr, T., Rasoul, H., Asghar, T., Sh, E., Naser, A., Behrooz, N. and Hossein, S.K. 2019. Inhibitory effect of isolated Lactobacillus from oral cavity against bacterial Pathogens and its effect on health promotion. Ars. Pharm. 60(1), 27–33; doi:10.30827/ars.v60i1.7943 Khalil, I.I. 2021. Fungal infections in Cyprinus carpio fish in Mosul city, Iraq. Vet. Practitioner. 2(22), 205–211; doi:10.21271/ZJPAS.37.1.7 Mugale, M., Bhat, A.A., Gavhane, D.S. and Bhat, S.A. 2015. Outbreaks of thrush in pigeons in Punjab State of India. Comparative. Clin. Pathol. 24(3), 635–638; doi:10.1007/s00580-014-1958-y Oliveira, V.M.C., Santos, S.S.F., Silva, C.R.G., Jorge, A.O.C. and Leão, M.V.P. 2016. Lactobacillus is able to alter the virulence and the sensitivity profile of Candida albicans. J. Appl. Microbiol. 121(6), 1737–1744; doi:10.1111/jam.13289 Petricevic, L., Domig, K.J., Nierscher, F.J., Krondorfer, I., Janitschek, C., Kneifel, W. and Kiss, H. 2021. Characterisation of the oral, vaginal and rectal Lactobacillus flora in healthy pregnant and postmenopausal women. Europ. J. Obst. Gynecol. Reprod. Biol. 160(1), 93–99; doi:10.1016/j.ejogrb.2011.10.002 Razmyar, J., Movassaghi, A.R., Mirshahi, A., Eidi, S. and Zaeemi, M. 2014. Osteoarthritis and systemic infection caused by Candida albicans in a common Mynah (Acridotheres tristis). Iranian J. Vet. Sci. Technol. 6(2), 77–84; doi:10.22067/veterinary.v6i2.27859 Salari, Ghasemi Nejad Almani, P. 2020. Antifungal effects of Lactobacillus acidophilus and Lactobacillus plantarum against different oral Candida species isolated from HIV/AIDS patients: an in vitro study. J. Oral Microbiol. 12; doi:10.1080/20002297.2020.1769386 Samour, J.H. and Naldo, J.L. 2002. Diagnosis and therapeutic management of candidiasis in falcons in Saudi Arabia. J. Avian Med. Surg. 16(2), 129–132. Silva, M.P., Rossoni, R.D., Junqueira, J.C. and Jorge, A.O.C. 2016. Probiotics for Prevention and Treatment of Candidiasis and Other Infectious Diseases: lactobacillus spp. And Other Potential Bacterial Species.In Department of Biosciences and Oral Diagnosis Institute of Science and Technology. São Paulo, Brazil; doi: 10.5772/64093 Steve, 2006. Discovering statistics using SPSS (2nd edition). Andy Field, London: sage. Publications Ltd. 2nd ed., London, UK: Sage, 76, p 423; doi: 10.1348/000709906X100611 Tabasco, R., Paarup, T., Janer, C., Peláez, C. and Requena, T. 2007. Selective enumeration and identification of mixed cultures of Streptococcus thermophilus, Lactobacillus delbrueckii subsp. bulgaricus, L. acidophilus, L. paracasei subsp. Paracasei and Bifidobacterium lactis in fermented milk. Int. Dairy. J. 17(9), 1107–1114; doi:10.1016/j.idairyj.2007.01.010 Vieira, R.G. and Coutinho, S.D.A. 2009. Phenotypical characterization of Candida spp. isolated from crop of parrots (Amazona spp.). Pesquisa Veterinária Brasileira 29(6), 452–456; doi:10.1590/S0100-736X2009000600002 Vijay, J.J. and Mahendra, P. 2006. Canine mycotic stomatitis due to Candida albicans. Rev. Iberoam. Micol. 23, 233–234; doi:10.1016/s1130-1406(06)70050-x | ||
| How to Cite this Article |
| Pubmed Style Qader HAH, Al_saeedi NAAA, Al-tamimi SMK, Al-abedi HFH, Khalil II. Lactobacillus acidophilus as an antifungal against Candida albicans isolated from Pycnonotus goiavier (Yellow-Vented Bulbul) thrush. Open Vet. J.. 2026; 16(3): 1678-1686. doi:10.5455/OVJ.2026.v16.i3.25 Web Style Qader HAH, Al_saeedi NAAA, Al-tamimi SMK, Al-abedi HFH, Khalil II. Lactobacillus acidophilus as an antifungal against Candida albicans isolated from Pycnonotus goiavier (Yellow-Vented Bulbul) thrush. https://www.openveterinaryjournal.com/?mno=289828 [Access: June 22, 2026]. doi:10.5455/OVJ.2026.v16.i3.25 AMA (American Medical Association) Style Qader HAH, Al_saeedi NAAA, Al-tamimi SMK, Al-abedi HFH, Khalil II. Lactobacillus acidophilus as an antifungal against Candida albicans isolated from Pycnonotus goiavier (Yellow-Vented Bulbul) thrush. Open Vet. J.. 2026; 16(3): 1678-1686. doi:10.5455/OVJ.2026.v16.i3.25 Vancouver/ICMJE Style Qader HAH, Al_saeedi NAAA, Al-tamimi SMK, Al-abedi HFH, Khalil II. Lactobacillus acidophilus as an antifungal against Candida albicans isolated from Pycnonotus goiavier (Yellow-Vented Bulbul) thrush. Open Vet. J.. (2026), [cited June 22, 2026]; 16(3): 1678-1686. doi:10.5455/OVJ.2026.v16.i3.25 Harvard Style Qader, H. A. H., Al_saeedi, . N. A. A. A., Al-tamimi, . S. M. K., Al-abedi, . H. F. H. & Khalil, . I. I. (2026) Lactobacillus acidophilus as an antifungal against Candida albicans isolated from Pycnonotus goiavier (Yellow-Vented Bulbul) thrush. Open Vet. J., 16 (3), 1678-1686. doi:10.5455/OVJ.2026.v16.i3.25 Turabian Style Qader, Huda A. H., Nabaa Ali Abd Alradha Al_saeedi, Salam Mohammed Khlaif Al-tamimi, Hawraa F. H. Al-abedi, and Israa Ibrahim Khalil. 2026. Lactobacillus acidophilus as an antifungal against Candida albicans isolated from Pycnonotus goiavier (Yellow-Vented Bulbul) thrush. Open Veterinary Journal, 16 (3), 1678-1686. doi:10.5455/OVJ.2026.v16.i3.25 Chicago Style Qader, Huda A. H., Nabaa Ali Abd Alradha Al_saeedi, Salam Mohammed Khlaif Al-tamimi, Hawraa F. H. Al-abedi, and Israa Ibrahim Khalil. "Lactobacillus acidophilus as an antifungal against Candida albicans isolated from Pycnonotus goiavier (Yellow-Vented Bulbul) thrush." Open Veterinary Journal 16 (2026), 1678-1686. doi:10.5455/OVJ.2026.v16.i3.25 MLA (The Modern Language Association) Style Qader, Huda A. H., Nabaa Ali Abd Alradha Al_saeedi, Salam Mohammed Khlaif Al-tamimi, Hawraa F. H. Al-abedi, and Israa Ibrahim Khalil. "Lactobacillus acidophilus as an antifungal against Candida albicans isolated from Pycnonotus goiavier (Yellow-Vented Bulbul) thrush." Open Veterinary Journal 16.3 (2026), 1678-1686. Print. doi:10.5455/OVJ.2026.v16.i3.25 APA (American Psychological Association) Style Qader, H. A. H., Al_saeedi, . N. A. A. A., Al-tamimi, . S. M. K., Al-abedi, . H. F. H. & Khalil, . I. I. (2026) Lactobacillus acidophilus as an antifungal against Candida albicans isolated from Pycnonotus goiavier (Yellow-Vented Bulbul) thrush. Open Veterinary Journal, 16 (3), 1678-1686. doi:10.5455/OVJ.2026.v16.i3.25 |